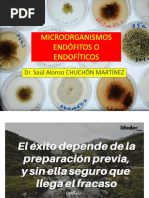

CLASIFICACIÓN DE LOS SERES VIVOS
Los seres vivos se clasifican de acuerdo a las características que presenten, la Taxonomía es la parte de la biología que se
encarga de este tema y los divide en los cinco (5) reinos de los seres vivos.
Reino Mónera: Los organismos que forman este reino son unicelulares, no tienen núcleo definido (Procarióticas)
forman dos grandes grupos o filum.
Bacterias: Son los seres vivos más pequeños que se conocen algunos de ellos producen enfermedades
infecciosas como el cólera, gonorrea, tuberculosis etc.
Algas Verdes Azules: Son algas microscópicas que se encuentran en aguas estancadas o con poco oxígeno en
cambio de clorofila (verde) tienen un pigmento azul llamado ficocianina que da el color azul
Reino Protisto: Estos organismos unicelulares se caracterizan por presentar cualidades tanto de animales como de
plantas. Sus células tienen núcleo definido. Es decir que son eucarióticas. Un ejemplo de este grupo es la amiba.
Reino Fungí: En este reino encontramos a los hongos que son organismos parecidos a las plantas, pero incapaces de
fabricar su alimento, se nutre de otros seres vivos o de materia orgánica en descomposición son saprofitos en su mayoría.
Los hongos por lo general son pluricelulares, sus células son eucarióticas y presentan pared celular. Entre ellos
encontramos algunos comestibles cono el champiñón, arrellanas y otros que producen enfermedades de la piel como el
pide de atleta o los sabañones, los mohos que descomponen las frutas y las verduras, y los utilizados en la preparación del
pan.
Reino Vegetal: Las plantas son organismos pluricelulares. Realizan fotosíntesis para producir su propio alimento. Es
decir que son autótrofas, sus células tienen pared celular, dentro de este reino existen dos grandes divisiones o filum.
Briofitas: Son pequeñas plantas que no tienen tejidos para la conducción de sustancias. Se encuentran en
lugares húmedos y algunas son acuáticas. En este grupo están los musgos y las hepáticas.
Traqueófitas: Son plantas vasculares. Es decir, tienen vasos para conducir el agua y los alimentos. En este filum
se encuentran los helechos, los pinos y las plantas con flores.
�Reino Animal: Los representantes de este reino son pluricelulares, no producen su alimento (Heterótrofos), sus células
no tienen pared celular y son eucarióticas, la membrana celular es delgada y elástica. Este reino presenta dos grandes
divisiones; invertebrados y vertebrados. Los invertebrados no tienen columna vertebral ni huesos.
Los invertebrados se dividen en varios grupos. Entre los más importantes están:
Poríferos:(Esponjas de mar) Tienen muchos poros por donde reciben el Celenterados:Son de vida marina forman los arrecifes
oxigeno y los alimentos: Son de vida marina. coralinos como los corales.
Platelmintos:Gusanos planos que pueden vivir libremente en el agua Asquelmintos:Gusanos de cuerpo cilíndrico entre ellos
como la planaria o ser parásito como la Tenia o Solicitaría. tenemos la lombriz intestinal o áscaris.
Anélidos: Gusanos con el cuerpo segmentado o con divisiones como la Artrópodos:Organismos con pies articulados dentro de
lombriz de tierra estos encontramos a los insectos.
� Los Vertebrados: Son animales que tienen columna vertebral y esqueleto óseo. Dentro de los vertebrados
encontramos los siguientes grupos:
Peces: Como el bagre, tiburón, son acuáticos con respiración bronquial
Anfibios: Viven en la tierra como en el agua, ejemplo; el sapo, la rana
Reptiles: Como la tortuga, el caimán, la iguana y la serpiente, son animales de piel seca y cuerpo
cubierto de escamas, posee pulmones.
Aves: Como las palomas, el colibrí y el avestruz, tienen el cuerpo cubierto de plumas, pico, esqueleto
óseo y pulmones.
Mamíferos: Como el caballo, el puma, la ballena y el murciélago, posee por lo general cuerpo cubierto
de pelos; las hembras presentan glándulas mamarías.
Taller de lectura
1. ¿En cuantos reinos se clasifican los seres vivos?
2. ¿Cómo se llama la parte de la biología que se encarga de la clasificación de los seres vivos?
3. ¿Cómo son los organismos que forman el reinó mónera?
4. ¿Qué son bacterias? ¿Qué enfermedades producen algunas de ellas?
5. ¿Qué son algas verde azules?
6. ¿Cómo son los organismos pertenecientes al reino protista?
7. ¿Qué organismos encontramos en el reino fungi?
8. ¿Qué son hongos? De ejemplos de hongos comestibles, de los que producen enfermedades y de mohos
9. ¿Qué son plantas, que proceso realizan, como son sus células?
10. ¿Qué son plantas briófitas? De dos ejemplos
11. ¿Qué son plantas traqueófitas? De dos ejemplos
12. Del reino animal responda:
a. ¿Cómo son los representantes de este grupo?
b. ¿Cómo son sus células?
c. ¿Qué divisiones presenta este grupo?
13. Escriba la definición de cada uno de los siguientes grupos de organismos: poríferos, celenterados,
platelmintos, asquelmintos, anélidos y artrópodos.
14. Escriba ejemplos y características de peces, anfibios, reptiles, aves y mamíferos.
15. Copie con su descripción cada uno de los 9 dibujos y decórelos con los colores que usted prefiera.